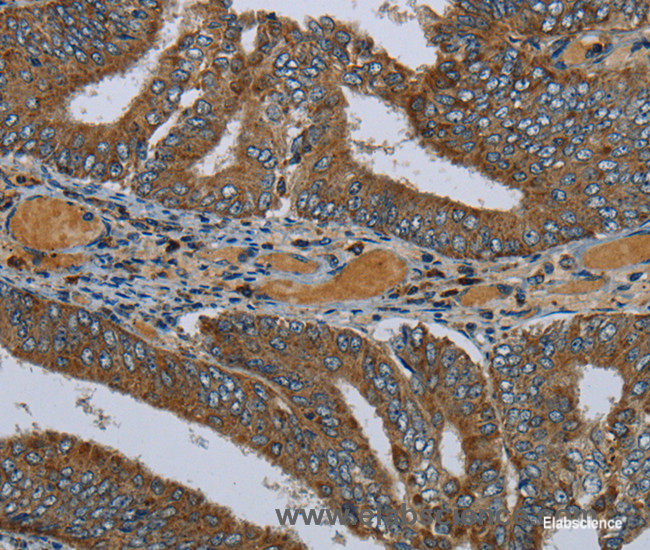

PCK2Ôľąphosphoenolpyruvate carboxykinase 2, mitochondrial„ÄĀPEPCK-MԾȄĀĮ„ÄĀ„Éõ„āĻ„Éõ„ā®„Éé„Éľ„Éę„ÉĒ„Éę„Éď„É≥ťÖł„āę„Éę„Éú„ā≠„ā∑„ā≠„Éä„Éľ„āľÔľąPCK„ÄĀPEPCKԾȄĀģ„āĘ„ā§„āĹ„ā∂„ā§„Ɇ„Āģ1„Ā§„Āß„Āā„āä„ÄĀ„Éí„Éą„Āß„ĀĮ14Áē™śüďŤČ≤šĹď„ĀęšĹćÁĹģ„Āô„āčPCK2ťĀļšľĚŚ≠ź„Āę„āą„Ā£„Ā¶„ā≥„Éľ„ÉČ„Āē„āĆ„āč„Äā„Āď„ĀģťĀļšľĚŚ≠ź„ĀĮ„ÄĀ„āį„āĘ„Éé„ā∑„É≥šłČ„É™„É≥ťÖłÔľąGTPԾȄĀģŚ≠ėŚú®šłč„Āß„ā™„ā≠„āĶ„É≠ťÖĘťÖłÔľąOAAԾȄĀč„āČ„Éõ„āĻ„Éõ„ā®„Éé„Éľ„Éę„Éď„Éę„Éď„É≥ťÖłÔľąPEPԾȄĀł„ĀģŚ§ČśŹõ„āíŤß¶Ś™í„Āô„āč„Éü„Éą„ā≥„É≥„ÉČ„É™„āĘ„ĀģťÖĶÁī†„āí„ā≥„Éľ„ÉČ„Āô„āč„ÄāÁīįŤÉěŤ≥™ŚüļŤ≥™Śěč„Āģ„āĘ„ā§„āĹ„ā∂„ā§„ɆԾąPCK1ԾȄĀĮÁēį„Ā™„āčťĀļšľĚŚ≠ź„Āę„āą„Ā£„Ā¶„ā≥„Éľ„ÉČ„Āē„āĆ„ÄĀ„Āď„Ā°„āČ„ĀĮŤāĚŤáď„Āß„ĀģÁ≥ĖśĖįÁĒü„Āęťá捶Ā„Ā™ťÖĶÁī†„Āß„Āā„āč„ÄāťĀłśäěÁöĄ„āĻ„Éó„É©„ā§„ā∑„É≥„āį„Āę„āą„āč„Éź„É™„āĘ„É≥„Éą„ĀĆŤ®ėŤľČ„Āē„āĆ„Ā¶„ĀĄ„āč„Äā
śßčťÄ†
PCK2ťĀļšľĚŚ≠ź„ĀĮ„Éü„Éą„ā≥„É≥„ÉČ„É™„āĘŚěč„ĀģPCK„āí„ā≥„Éľ„ÉČ„Āó„ÄĀPCK1ťĀļšľĚŚ≠ź„Ā®„ĀģDNAťÖ挹ó„ĀģŚźĆšłÄśÄß„ĀĮ68%„ÄĀÁīįŤÉěŤ≥™ŚüļŤ≥™ŚěčPCK1„Ā®„Āģ„āĘ„Éü„ÉéťÖłťÖ挹ó„ĀģŚźĆšłÄśÄß„ĀĮ70%„Āß„Āā„āč„Äā„Āē„āČ„Āę„ÄĀPCK1„Ā®PCK2„Āę„ĀĮśßčťÄ†ÁöĄÁõłŚźĆśÄß„ĀĆ„ĀŅ„āČ„āĆ„ÄĀŚÖĪťÄö„Āó„ĀüÁ•ĖŚÖąťĀļšľĚŚ≠ź„ĀęÁĒĪśĚ•„Āô„āčťĀļšľĚŚ≠ź„Āß„Āā„āč„Āď„Ā®„ĀĆÁ§ļŚĒÜ„Āē„āĆ„āč„Äā„Ā©„Ā°„āČ„ĀģťĀļšľĚŚ≠ź„āā10ŚÄč„Āģ„ā®„āĮ„āĹ„É≥„Ā®9ŚÄč„Āģ„ā§„É≥„Éą„É≠„É≥„āíśĆĀ„Ā§„ĀĆ„ÄĀ„ā§„É≥„Éą„É≠„É≥„Āģ„āĶ„ā§„āļ„ĀĮÁīĄ2 kb„āāÁēį„Ā™„āä„ÄĀPCK2„ĀģśúÄŚ§ß„Āģ„ā§„É≥„Éą„É≠„É≥„ĀĮ2.5 kb„Āę„āŹ„Āü„āč„ÄāPCK2ťĀļšľĚŚ≠ź„ĀģŚÖ®ťē∑„ĀĮÁīĄ10 kb„Āß„Āā„āč„ÄāšĽĖ„ĀģŚ∑ģÁēį„Ā®„Āó„Ā¶„ĀĮ„ÄĀPCK2„Āģ„ā§„É≥„Éą„É≠„É≥„Āę„ĀĮPCK1„ĀęŚ≠ėŚú®„Āó„Ā™„ĀĄAluťÖ挹ó„ĀĆŚ≠ėŚú®„Āô„āč„Äā„Āĺ„Āü„ÄĀPCK2„ĀģNśúęÁęĮ„Āę„ĀĮ18śģčŚüļ„Āģ„Éü„Éą„ā≥„É≥„ÉČ„É™„āĘś®ôÁöĄŚĆĖťÖ挹ó„ĀĆŚ≠ėŚú®„Āô„āč„ÄāPCK2„ĀģŤĽĘŚÜôťĖčŚßčťÉ®šĹć„Āģ1819 bpšłäśĶĀ„Āę„ĀĮ„ÄĀ5ŚÄč„ĀģGC„Éú„ÉÉ„āĮ„āĻ„Ā®3ŚÄč„ĀģCCAAT„Éú„ÉÉ„āĮ„āĻ„ā팟ę„āĜ鮌ģöŤ™ŅÁĮÄ„ā®„ɨ„É°„É≥„Éą„ĀĆŚ≠ėŚú®„Āô„āč„Äā„Āē„āČ„Āę„ÄĀŤŅĎšĹć„Éó„É≠„ÉĘ„Éľ„āŅ„Éľť†ėŚüü„Āę„ĀĮATF4„ĀĆÁĶźŚźą„Āô„āč2„Ā§„ĀģATF/CREťÖ挹ó„ĀĆŚ≠ėŚú®„Āô„āč„Ā®śé®Śģö„Āē„āĆ„āč„Äā
ś©üŤÉĹ
PCK2„ĀĮGTP„Āę„āą„Ā£„Ā¶ťßÜŚčē„Āē„āĆ„ÄĀÁ≥ĖśĖįÁĒü„ĀģŚĺčťÄüśģĶťöé„Āß„Āā„āčOAA„Āč„āČPEP„Āł„ĀģŚ§ČśŹõ„āíŤß¶Ś™í„Āô„āč„Äā„Āď„ĀģŚ§ČśŹõśģĶťöé„ĀĮ„ÄĀ„Éü„Éą„ā≥„É≥„ÉČ„É™„āĘ„Āę„Āä„ĀĄ„Ā¶Ťß£Á≥ĖÁ≥Ľ„Ā®TCAŚõěŤ∑Į„āíś©čśł°„Āó„Āô„āčśģĶťöé„Ā®„Āó„Ā¶ś©üŤÉĹ„Āô„āč„ÄāŤÜĶŤáď„Āģő≤ÁīįŤÉě„Āß„ĀĮ„ÄĀPCK2„ĀĮ„āĻ„āĮ„ā∑„Éč„ÉęCoA„ā∑„É≥„ÉÜ„āŅ„Éľ„āľ„Āę„āą„Ā£„Ā¶ÁĒ£ÁĒü„Āē„āĆ„ĀüGTP„āí„É™„āĶ„ā§„āĮ„Éę„Āô„āč„Āď„Ā®„Āß„ÄĀ„āį„Éę„ā≥„Éľ„āĻŚąļśŅÄ„Āę„āą„āč„ā§„É≥„āĻ„É™„É≥ŚąÜś≥Ć„ā퍙ŅÁĮÄ„Āô„āč„ÄāPCK2„ĀģśīĽśÄß„ĀĮ„ÄĀ„āĮ„ā®„É≥ťÖł„ā∑„É≥„āŅ„Éľ„āľ„ĀłŚźĎ„ĀĎ„Ā¶„āĘ„āĽ„ÉĀ„ÉęCoA„āíšĺõÁĶ¶„Āô„āč„Āü„āĀ„Āę„ÉĒ„Éę„Éď„É≥ťÖłŚĹĘśąź„Āģ„Āü„āĀ„ĀģPEP„āíšĺõÁĶ¶„Āó„ÄĀTCAŚõěŤ∑Į„āíťßÜŚčē„Āô„āč„ÄāPEP„ĀģšłäśĶĀ„Ā®„āį„Éę„ā≥„Éľ„āĻ-6-„É™„É≥ťÖł„ĀģšłčśĶĀ„ĀģŤß£Á≥ĖÁ≥ĽŚŹćŚŅú„Āģ„ĀĽ„ĀľŚÖ®„Ā¶„ĀĆŚŹĮťÄÜÁöĄ„Āß„Āā„āč„Āü„āĀ„ÄĀPCK2„Āę„āą„āčPEP„ĀģŚźąśąź„ĀĮ„ÄĀ„āĽ„É™„É≥Śźąśąź„ÄĀ„āį„É™„āĽ„É≠„Éľ„Éꌟąśąź„ÄĀ„ÉĆ„āĮ„ɨ„ā™„ÉĀ„ÉČŚźąśąź„Ā™„Ā©Ť§áśēį„ĀģÁĒüŚźąśąźťĀéÁ®č„āíŚä†ťÄü„Āô„ā茏ĮŤÉĹśÄß„ĀĆ„Āā„āč„ÄāÁČĻ„Āę„ÄĀPCK2„ĀĮšĻ≥ťÖł„ĀęÁĒĪśĚ•„Āô„āčOAA„āíťĀłśäěÁöĄ„ĀꌧȜŹõ„Āô„āč„Āü„āĀ„ÄĀšĹé„āį„Éę„ā≥„Éľ„āĻśĚ°šĽ∂šłč„Āß„āāÁĒüŚźąśąź„āíšŅÉťÄ≤„Āô„āč„Āď„Ā®„ĀĆ„Āß„Āć„āč„ÄāÁĶźśěú„Ā®„Āó„Ā¶„ÄĀPCK2„ĀģśīĽśÄß„ĀĮÁīįŤÉěśąźťē∑„Ā®„āĻ„Éą„ɨ„āĻšłč„Āß„ĀģÁĒüŚ≠ė„ĀęŚĮĄšłé„Āô„āč„Äā
PCK1„ĀĆšłĽ„ĀęŤāĚŤáď„Ā®ŤÖéŤáď„ĀßÁôļÁŹĺ„Āó„Ā¶„ĀĄ„āč„Āģ„ĀęŚĮĺ„Āó„ÄĀPCK2„ĀĮ„Āē„Āĺ„ĀĖ„Āĺ„Ā™ÁīįŤÉěÁ®ģ„ĀßśôģťĀćÁöĄ„ĀęÁôļÁŹĺ„Āó„Ā¶„ĀĄ„āč„ÄāÁôĹŤ°ÄÁźÉ„āĄÁ•ěÁĶĆÁīįŤÉě„Āģ„ĀĽ„Āč„ÄĀŤÜĶŤáď„ÄĀŤĄ≥„ÄĀŚŅÉŤáď„Ā™„Ā©Á≥ĖśĖįÁĒü„ā퍰ƄāŹ„Ā™„ĀĄÁĶĄÁĻĒ„Āß„āāÁôļÁŹĺ„ĀĆ„ĀŅ„āČ„āĆ„āč„Äā„Āē„āČ„Āę„ÄĀPCK1„ĀģÁôļÁŹĺ„ĀĮÁ≥ĖśĖįÁĒü„Ā®ťĖĘšŅā„Āô„āč„Éõ„Éę„ÉĘ„É≥„āĄś†Ąť§äÁī†„Āę„āą„Ā£„Ā¶Ť™ŅÁĮÄ„Āē„āĆ„Ā¶„ĀĄ„āč„Āģ„ĀęŚĮĺ„Āó„ÄĀPCK2„ĀĮśĀ팳łÁöĄ„ĀęÁôļÁŹĺ„Āó„Ā¶„ĀĄ„āč„Äā„Āď„āĆ„āČ„ĀģŚ∑ģÁēį„ĀĮ„ÄĀPCK2„ĀĆÁ≥ĖśĖįÁĒüšĽ•Ś§Ė„Āģś©üŤÉĹ„āāśěú„Āü„Āó„Ā¶„ĀĄ„ā茏ĮŤÉĹśÄß„āíÁ§ļŚĒÜ„Āó„Ā¶„ĀĄ„āč„Äā
Ťá®ŚļäÁöĄśĄŹÁĺ©
PCK2„ĀĮŤāļ„ĀĆ„āď„Ā™„Ā©„ĀĄ„ĀŹ„Ā§„Āč„Āģ„ĀĆ„āď„Ā®ťĖĘšŅā„Āó„Ā¶„Āä„āä„ÄĀ„ĀĚ„ĀģÁ≥ĖśĖįÁĒüś©üŤÉĹ„Āę„āą„Ā£„Ā¶ŤÖęÁėćŚĹĘśąź„āíšŅÉťÄ≤„Āô„āč„ÄāšĹé„āį„Éę„ā≥„Éľ„āĻśĚ°šĽ∂šłč„Āß„ĀĮ„ÄĀŚįŹŤÉěšĹď„āĻ„Éą„ɨ„āĻ„Āę„āą„Ā£„Ā¶ATF4„ĀĆ„āĘ„ÉÉ„Éó„ɨ„āģ„É•„ɨ„Éľ„ā∑„Éß„É≥„Āē„āĆ„ÄĀ„ĀĚ„āĆ„Āę„āą„Ā£„Ā¶PCK2„ĀĆ„āĘ„ÉÉ„Éó„ɨ„āģ„É•„ɨ„Éľ„ā∑„Éß„É≥„Āē„āĆ„āč„ÄāPCK2„ĀĮTCAŚõěŤ∑Į„Āģšł≠ťĖďšĹď„āíŤß£Á≥ĖÁ≥Ľ„Āģšł≠ťĖďšĹď„ĀꌧȜŹõ„Āô„ā蚼£śõŅÁöĄ„āę„āŅ„Éó„ɨ„É≠„ÉÜ„ā£„ÉÉ„āĮÁĶĆŤ∑Į„ĀģŚą©ÁĒ®„ā팏ĮŤÉĹ„Āę„Āô„āč„Āü„āĀ„ÄĀPCK2„ĀģśīĽśÄß„ĀĮ„āį„Éę„ā≥„Éľ„āĻ„ɨ„Éô„Éę„ĀģšĹéšłč„ĀęÁõīťĚĘ„Āó„ĀüŤÖęÁėćÁīįŤÉě„ĀģÁĒüŚ≠ė„āíšŅÉťÄ≤„Āô„ā茏ĮŤÉĹśÄß„ĀĆ„Āā„āč„Äā
PCK2„ĀĮÁ≥ĖśĖįÁĒüś©üŤÉĹ„āíśĆĀ„Ā§„Āü„āĀ„ÄĀPCK2„Āģś¨†šĻŹ„ĀĮ„āį„Éę„ā≥„Éľ„āĻ„ĀģśĀ팳łśÄß„āíÁ†īŚ£ä„Āó„ÄĀšĹ鍰ÄÁ≥Ė„ā팾ē„ĀćŤĶ∑„Āď„Āô„Āď„Ā®„ĀĆšļąśÉ≥„Āē„āĆ„āč„Äā2šĽ∂„ĀģÁóášĺč„ĀĆŤ®ėŤľČ„Āē„āĆ„Ā¶„ĀĄ„āč„āā„Āģ„Āģ„ÄĀ„ĀĚ„ĀģŚĺĆ„ĀģÁ†ĒÁ©∂„Āč„āČ„ĀĮPCK2„Āģś¨†šĻŹ„ĀĆšłĽŚõ†„Āß„ĀĮ„Ā™„ĀĄ„Āď„Ā®„ĀĆÁ§ļŚĒÜ„Āē„āĆ„Ā¶„ĀĄ„āč„Äā
ŚáļŚÖł
ťĖĘťÄ£ť†ÖÁõģ
- „Éõ„āĻ„Éõ„ā®„Éé„Éľ„Éę„ÉĒ„Éę„Éď„É≥ťÖł„āę„Éę„Éú„ā≠„ā∑„ā≠„Éä„Éľ„āľ
- PCK1